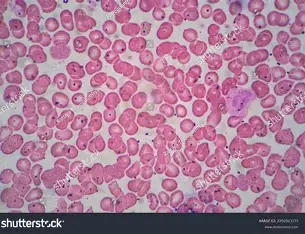
<p>Which kind of tissue is shown?</p>
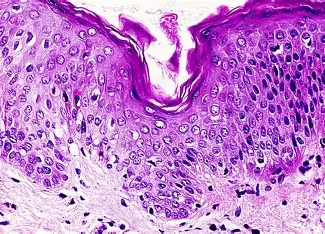
<p>Which kind of tissue is shown?</p>

Review 1 NOT COMPLETE
1/48
There's no tags or description
Looks like no tags are added yet.
Name | Mastery | Learn | Test | Matching | Spaced | Call with Kai |
|---|
No analytics yet
Send a link to your students to track their progress
49 Terms
Which kind of tissue is shown?
Blood

Which kind of tissue is shown?
Liver

Which kind of tissue is shown?
Cheek
Which kind of tissue is shown?
Skin

Which kind of tissue is shown?
Neuron
What are the different types of microscopes and their characteristic features?
Fluorescence Microscopy
Visualization of target proteins via fluorophores
Electron Microscopy
significantly higher resolution, high zoom, NO LIVE SAMPLE SINCE ITS IN A VACCUMM
Electron Cryo-microscopy
Allows for visualization of PROTEIN COMPLEXES, near atomic resolution
Super-resolution Microscopy
allows for visualization of molecular interactions
Confocal Microscopy
Uses PINHOLES to illuminate points of interest. HIGHER RESOLUTION AND CONTRAST THAN WIDEFIELD
Stochastic Optical Reconstruction
uses sets of fluoresence chemically tagged areas SWITCHED ON AND OFF, reproducing high 3D images
What is limit of resolution?
SPECIFIES RESOLVING POWER
LOR is the smallest distance by which two neighboring points can be separated and be observed as separate entities
What is resolving power?
This is the ABILITY of a microscope to distinguish two closely spaced points
What is Abbe’s Equation?
Used to calculate the LOR
l.r. = 0.61x wavelength / numerical aperture
As N.A. increases, resolving power increases
What is working distance?
This is the distance between the specimen and the objective lens
What is the formula for total magnification?
Eyepiece magnification x objective magnification
How do you calculate the average length of a cell using the magnification of microscope?
Field of View (FOV) / number of cells present in middle line
What is cell lysis?
This is the breaking open of a cell to release its contents
Can be broken open via mechanical methods, chemical, or sound waves
What is a lysate?
The LYSATE refers to the mixture of the cell components after being broken open
What is homogenization?
Homogenization is the breaking down of tissue to a single uniform substance TO BE THEN LYSED
What is a homogenate?
This is the result of breaking down tissue to a uniform solution
What are the steps to be followed for centrifugation?
Check the cap to make sure it is closed
Balance the centrifuge by placing the tubes opposite each other or substituting with a tube of equal mass
Set to RPM or G
Make sure the container is closed
What is cell fractionation?
This is the breaking open of cells and then separating based on SIZE AND DENSITY using CENTRIFUGATION
What is the supernatant?
After centrifugation, this is the liquid solution that was not pelleted
What is the purity of cell fractionation?
This refers to the purity of the cell component separated
The purity of the fraction collected
What is differential centrifugation?
This is the concept of different cell components being separated at different centrifugation speeds
How are the different cell components separated based on size and density with varying centrifugation speeds?
Different cell components must be separated one at a time
Low speed
Large dense cell components
Nuclei
Unbroken cells
Medium speed
Mitochondria
Lysosomes
Peroxisomes
High speed
MICROSOMES
golgi fragments
membrane vesicles
Very high speed
Ribosomes
Viruses
Proteasomes
What is SDS-PAGE
Sodium dodecyl sulfate - Polyacrylamide Gel Electrophoresis
Denatures proteins and gives them a uniform NEGATIVE charge to separate them BASED ON SIZE ALONE
What is the function of SDS
SDS is a DETERGENT that denatures proteins
Important for linearizing the proteins and assigning a negative charge
What is beta marceptoethanol used for?
Used in the SDS PAGE process
It is used to BREAK DISULFIDE BONDS S-S, helps in denaturing the proteins
What is bromophenol blue used for in the SDS PAGE process
It is usually a component of the LYSIS BUFFER
It is used to allow for the tracking of the proteins as they move through the gel by color
What is glycrol used for in the SDS PAGE process?
ADDS WEIGHT so that the protein sample can enter the gel well
Prevents the sample from dissolving
FOUND IN LYSIS BUFFER
What are the components of the Lysis Buffer
SDS
Glycerol
bromophenol blue
pH buffer
mercaptoethanol
What is the assembly of the blot stack during transfer
SDS PAGE gel is transferred to a MEMBRANE
Pad (either - or + depend on where the gel and membrane are) +
Filter paper
Membrane
Gel
Filter paper
Pad (-)
Remember the gel has (-) proteins so it must go from - to positive
What are the steps of western blot?
Perform electrophoresis to get gel
transfer gel to nitrocellulose membrane
Blocking buffer (Skim milk)
Incubate with primary antibody
wash buffer
incubate with secondary antibody
wash buffer
detect proteins
What is the function of western blot?
A Western blot tells us if our sample contains our target protein
ABUNDANCE OF THE PROTEIN AND SIZE OF THE PROTEIN
How do we prepare our samples for SDS-PAGE?
Extract target tissue
Add lysis buffer (opens the cells)
Add LAEMMLI BUFFER (contains the SDS, glycerol, mercaptoethanol, buffer, and bromophenol blue)
Heat
What are the types of buffer components for SDS PAGE and blot transfer?
Sample buffer (LAEMMLI BUFFER)
Running buffer
fills the gel tanks for SDS PAGE, allows proteins to migrate down
Gel Buffers
Tris HCl and SDS
Blocking buffer
DRY SKIM MILK
CASEIN-^
Wash Buffer
In SDS, what does the location of the protein band tell you?
The lower the band is = THE LIGHTER THE PROTEIN IS
What is a plasmid?
This is EXTRACHROMOSOMAL DNA that is circular and contains genetic information such as antibiotic resistance
What are restriction enzymes?
These are enzymes that cleave specific RESTRICTION SITES, yielding different pieces of DNA which can then be TRANSFORMED into a cell and attached to a plasmid
What is cloning?
This is the process of generating multiple copies of GENETICALLY IDENTICAL copies of DNA, cells, or organisms
What is a bacterial library, and how do we make genomic and cDNA libraries?
A bacterial library refers to a culture of bacteria, each with a plasmid containing a target gene
Genomic library
Many bacteria, each containing different parts of the human genome in their plasmid
cDNA library
Represents only the EXPRESSED genes
mRNA code only
What is Hydrophobic Interaction Chromatography?
HIC utilizes high salt conditions to bind the hydrophobic parts of a protein SUCH AS GFP
High salt = takes the water away resulting in hyrophobic regions being exposed, BINDING TO COLUMN
Low salt = attached protein is eluted out
What are the different buffers used in HIC
Binding buffer = HIGH SALT
Elution buffer = LOW SALT
What are the different stages of purification during HIC?
Equilibration - high salt, prepares the column
Binding buffer - very high salt, exposes nonpolar and causes binding
Wash - medium to high salt, washes weakly nonpolar CONTAMINANTS
Elution - Low salt, releases the hydrophobic protein
Role of antibiotic resistance gene such Ampicilin resistance gene in plasmid and their impact on
transformed bacterial growth
Antibiotic resistance gene in a plasmid ensures that only bacteria that have taken up the plasmid can reproduce
Therefore only the bacteria that have successfully transformed the plasmid can continue to grow
Role of inducer such as arabinose in lab engineered GFP bacteria
In GFP bacteria, arabinose is needed to bind to the GFP regulatory protein
HELPS TURN ON EXPRESSION
role of lysozyme
The lysozyme is used to break open cells, releasing its contents which can then be centrifuged to isolate the proteins in the supernatant
Quorum sensing, and their role in bacterial growth, survival and how to identify the different mutant strains and wild type
Quorum sensing is used in bacteria as cell to cell communication
They release and detect signaling molecules which help the bacterial colony identify when its reached critical growth